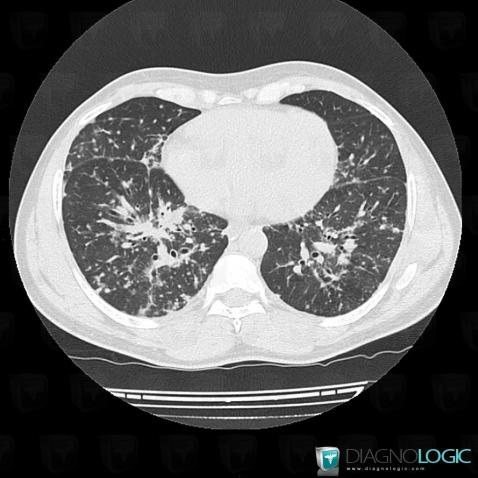
Sarcoïdose, Parenchyme pulmonaire, Scanner

Les images ci-dessous illustrent ce dossier pour les diagnostics Sarcoïdose, pour les modalités (Scanner)
Les gammes relatives à ce cas sont les suivantes : :
- Maladie prédominant en péri hilaire
- Condensation alvéolaire localisée
- Condensation alvéolaire chronique
- Epaississement péri broncho vasculaire / Epaississement septal irrégulier
- Adénomégalie hilaire
- Masse médiastinale contenant des calcifications

Voici les informations spécifiques à l'image clé ci dessus:
- Diagnostic Sarcoïdose, Localisation(s) Parenchyme pulmonaire, comportant les gammes Maladie prédominant en péri hilaire, Condensation alvéolaire localisée, Condensation alvéolaire chronique
Voici les informations spécifiques à l'image clé ci dessus:
- Diagnostic Sarcoïdose, Localisation(s) Parenchyme pulmonaire, comportant les gammes Epaississement péri broncho vasculaire / Epaississement septal irrégulier

Voici les informations spécifiques à l'image clé ci dessus:
- Diagnostic Sarcoïdose, Localisation(s) Parenchyme pulmonaire, comportant les gammes Maladie prédominant en péri hilaire, Condensation alvéolaire localisée, Condensation alvéolaire chronique

Voici les informations spécifiques à l'image clé ci dessus:
- Diagnostic Sarcoïdose, Localisation(s) Parenchyme pulmonaire, comportant les gammes Epaississement péri broncho vasculaire / Epaississement septal irrégulier

Voici les informations spécifiques à l'image clé ci dessus:
- Diagnostic Sarcoïdose, Localisation(s) Médiastin, comportant les gammes Adénomégalie hilaire, Masse médiastinale contenant des calcifications

Voici les informations spécifiques à l'image clé ci dessus:
- Diagnostic Sarcoïdose, Localisation(s) Médiastin, comportant les gammes Adénomégalie hilaire, Masse médiastinale contenant des calcifications